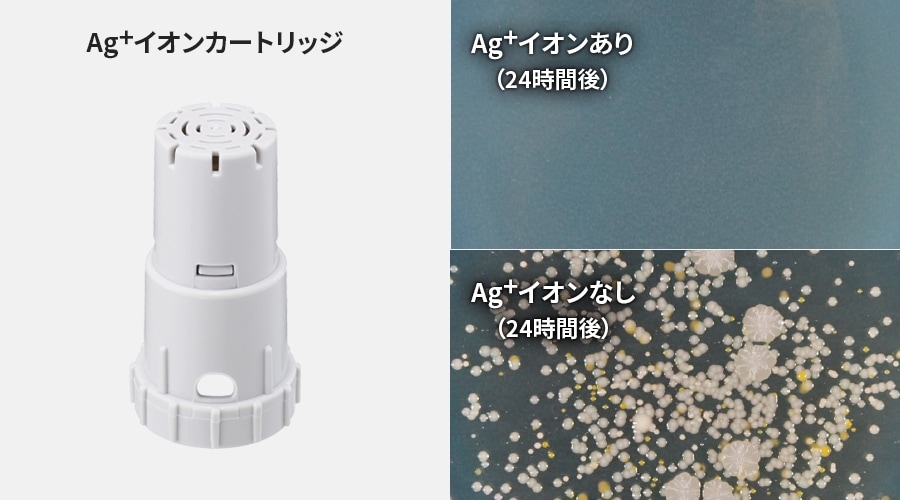
銀イオンあり、なしで24時間後の生菌数を比較した写真。銀イオンがない場合、菌が繁殖します。

加湿
乾燥が気になる季節にしっかり加湿
乾燥が気になる季節には、しっかり加湿。のどや鼻を乾燥から守ります。しかも、1日中加湿しても電気代は約3.4円(「弱」運転時)です。
- 電力料金目安単価31円/kWh(税込)[2022年7月改定](家電公取協調べ)で算出。

キレイにうるおう、清潔加湿
Ag⁺イオンカートリッジ
トレーに簡単装着できる「Ag⁺イオンカートリッジ」で、トレーのぬめりやニオイの原因となる水中の菌を抑制※1。1年に1回の交換でキレイが続きます。*
- 加湿空気清浄運転で1日当たり2.5Lを使用した場合の目安。水質・使用頻度により交換時期が早まる場合があります。また、実使用環境での実証結果ではありません。
抗菌※2・防カビ※3加湿フィルター
抗菌・防カビ加湿フィルターで清潔に加湿します。<交換の目安:5年*>
- 定格加湿能力に対し、加湿能力が50%に落ちるまでの時間。加湿空気清浄運転を1日8時間した場合の目安です。使用状況や洗い方によっては、寿命が早まることがあります。定期的(1ヶ月に1回程度)にフィルターのお手入れが必要です。 水質など使用環境によっては、早めにお手入れをしていただくことをおすすめします。

